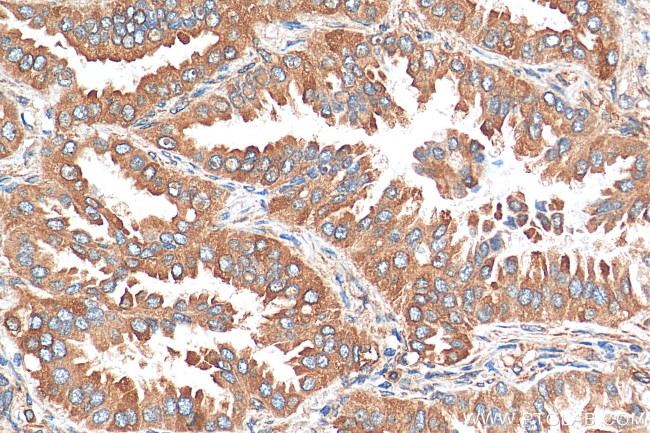
Kindlin 2 Antibody in Immunohistochemistry (Paraffin) (IHC (P))

Search
Proteintech
Kindlin 2 Polyclonal Antibody
{{$productOrderCtrl.translations['antibody.pdp.commerceCard.promotion.promotions']}}
{{$productOrderCtrl.translations['antibody.pdp.commerceCard.promotion.viewpromo']}}
{{$productOrderCtrl.translations['antibody.pdp.commerceCard.promotion.promocode']}}: {{promo.promoCode}} {{promo.promoTitle}} {{promo.promoDescription}}. {{$productOrderCtrl.translations['antibody.pdp.commerceCard.promotion.learnmore']}}
产品信息
29911-1-AP
种属反应
宿主/亚型
分类
类型
抗原
偶联物
形式
纯化类型
保存液
内含物
保存条件
运输条件
产品详细信息
Immunogen sequence: TSENHLNNSD KEVDEVDAAL SDLEITLEGG KTSTILGDIT SIPELADYIK VFKPKKLTLK GYKQYWCTFK DTSISCYKSK EESSGTPAHQ MNLRGCEVTP DVNISGQKFN I
靶标信息
Scaffolding protein that enhances integrin activation mediated by TLN1 and/or TLN2, but activates integrins only weakly by itself. Binds to membranes enriched in phosphoinositides. Enhances integrin-mediated cell adhesion onto the extracellular matrix and cell spreading; this requires both its ability to interact with integrins and with phospholipid membranes. Required for the assembly of focal adhesions. Participates in the connection between extracellular matrix adhesion sites and the actin cytoskeleton and also in the orchestration of actin assembly and cell shape modulation. Recruits FBLIM1 to focal adhesions. Plays a role in the TGFB1 and integrin signaling pathways. Stabilizes active CTNNB1 and plays a role in the regulation of transcription mediated by CTNNB1 and TCF7L2/TCF4 and in Wnt signaling. [UniProt]
仅用于科研。不用于诊断过程。未经明确授权不得转售。
篇参考文献 (0)
生物信息学
蛋白别名: Fermitin family homolog 2; fermitin family member 2; kindlin 2; Kindlin-2; MIG-2; mitogen inducible gene 2 protein; mitogen inducible gene-2; Mitogen-inducible gene 2 protein; PH domain-containing family C member 1; pleckstrin homology domain containing, family C (with FERM domain) member 1; pleckstrin homology domain containing, family C member 1; Pleckstrin homology domain-containing family C member 1; unnamed protein product
基因别名: FERMT2; KIND2; mig-2; MIG2; PLEKHC1; UNC112; UNC112B
UniProt ID: (Human) Q96AC1
Entrez Gene ID: (Human) 10979